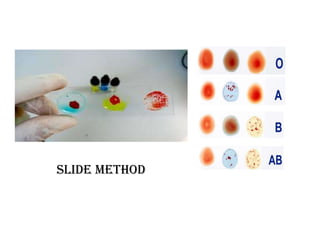
slide methOd

Embed presentation
Download as PDF, PPTX


























This document discusses different methods for blood typing including the slide method, gel technology method, and microplate testing methods. The slide method involves placing blood and reagents on a slide and observing reactions under a microscope. Gel technology and microplate testing methods automate blood typing by using gels or microplates and are commonly used in clinical settings.